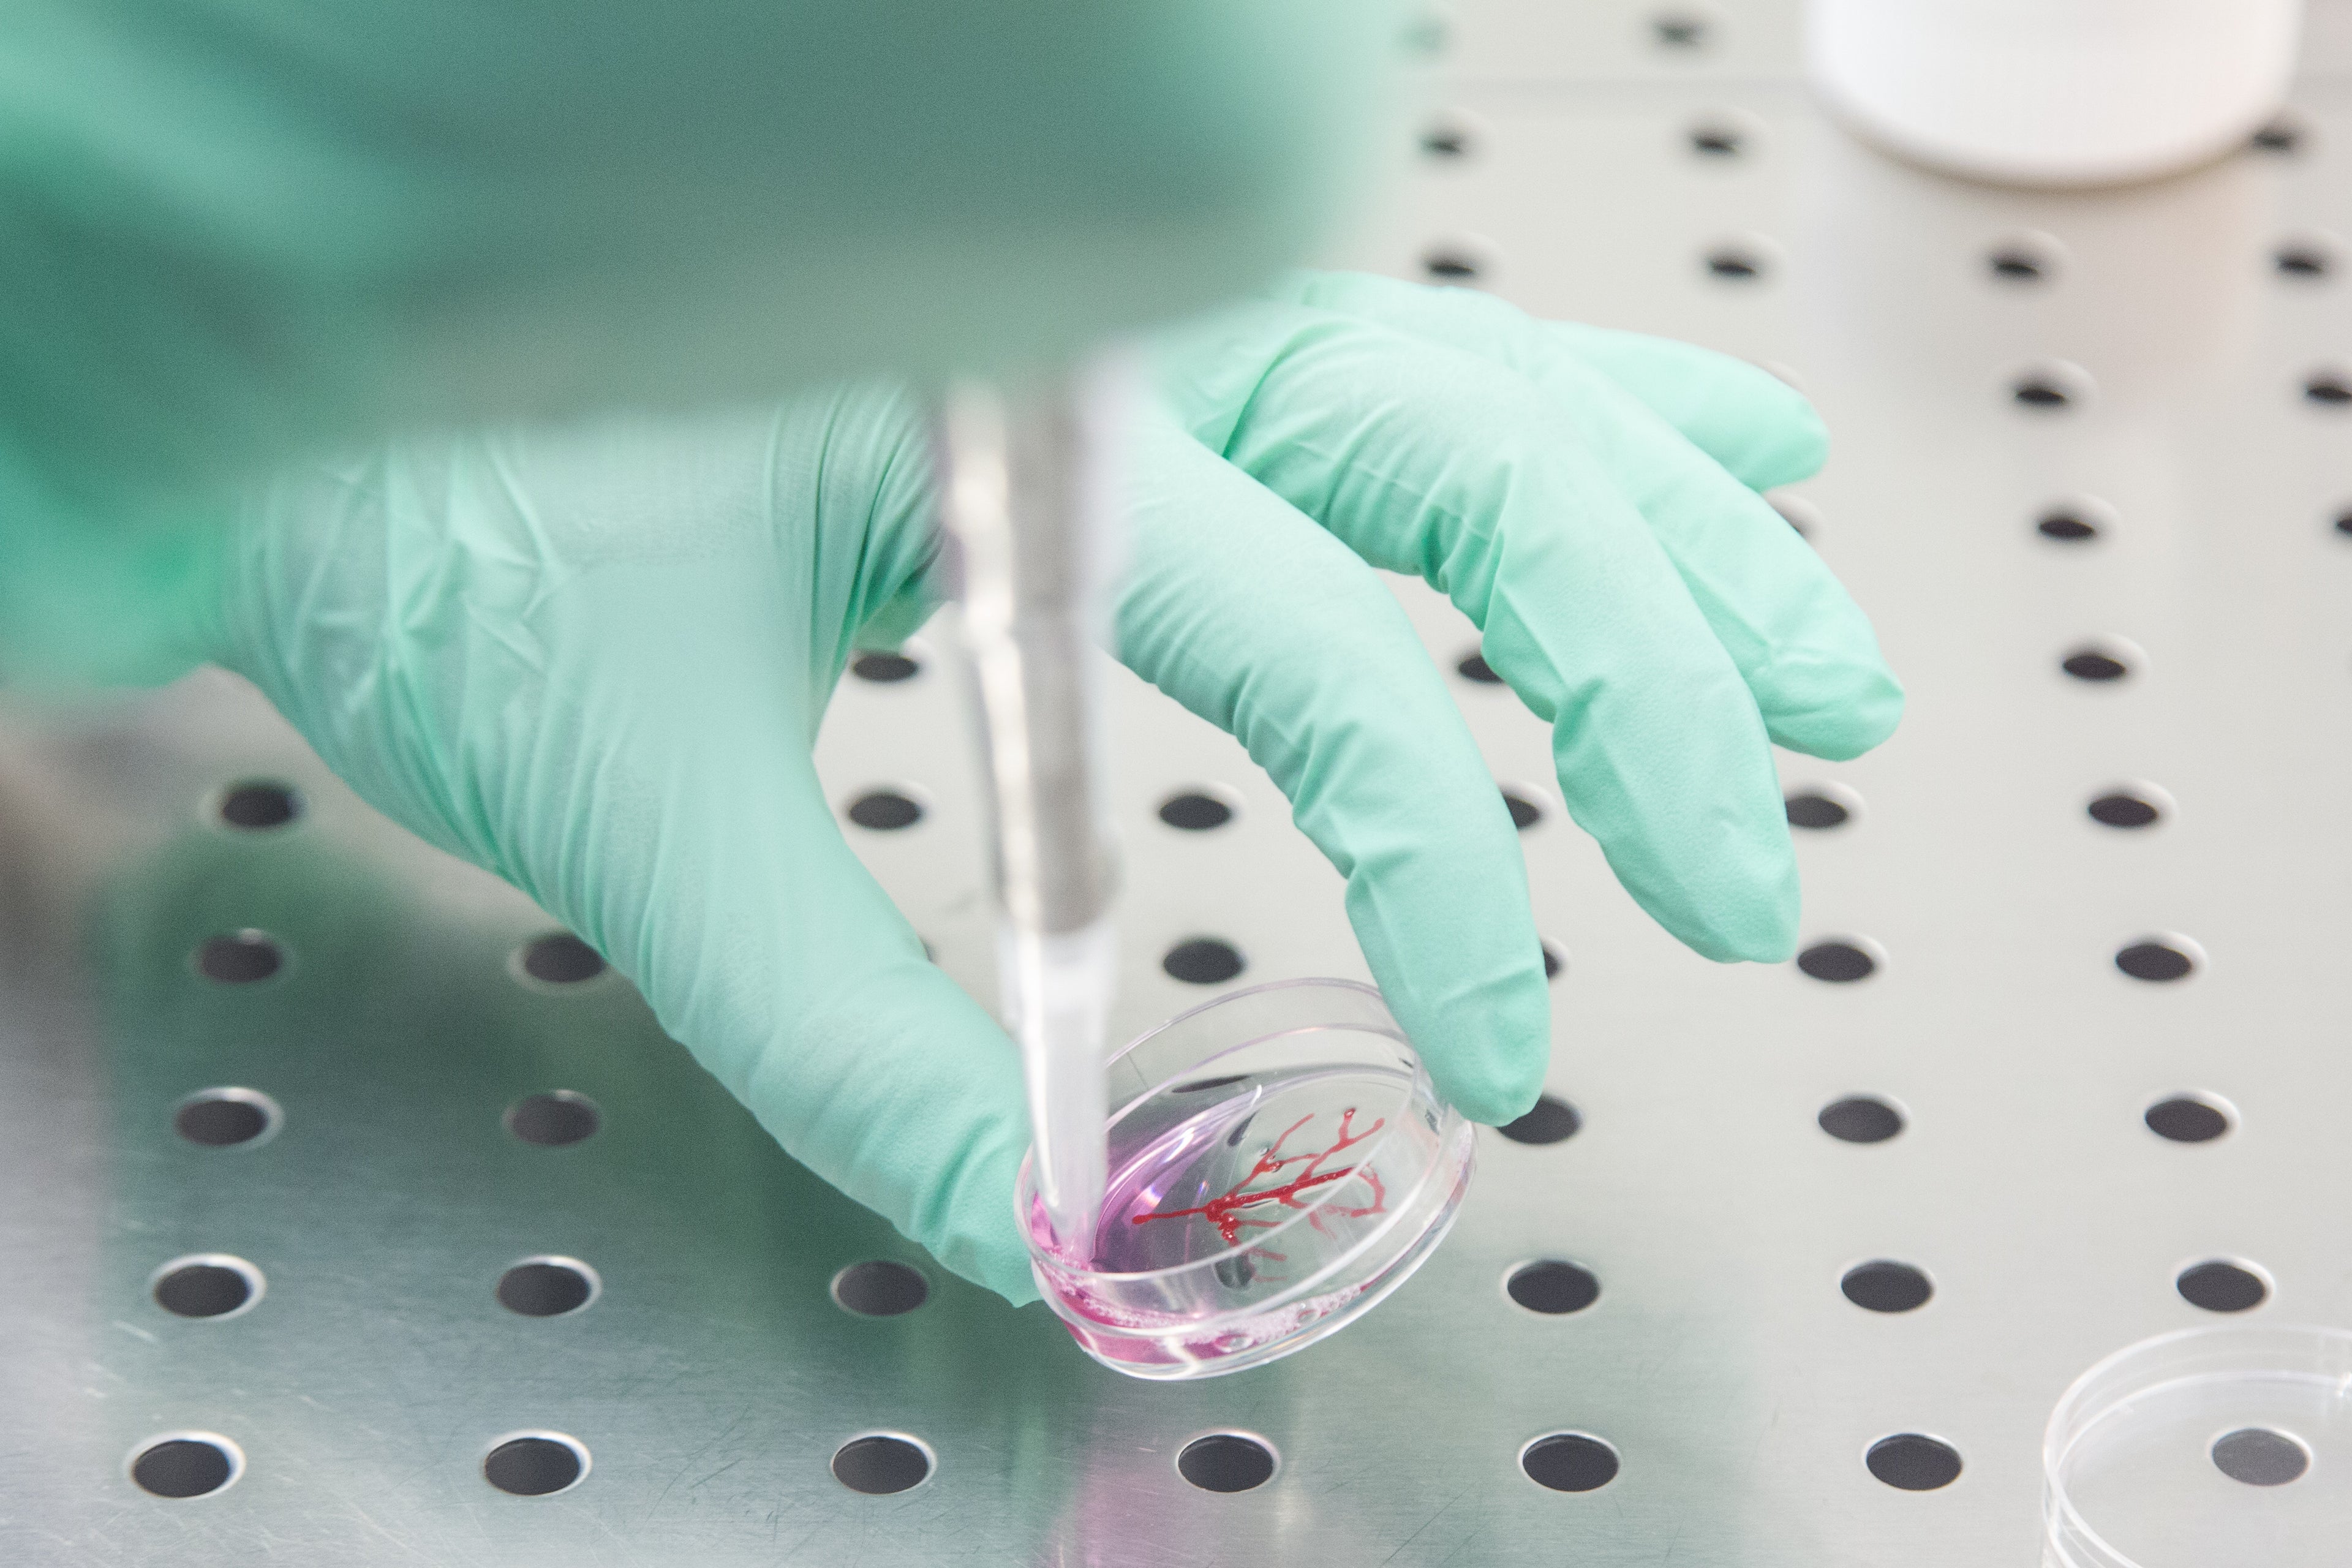

A New Paradigm in Drug Development

Introducing the OxygenControl Plates
Unlock Hypoxia and Physioxia Anywhere
Featured application
Ready-to-use Oxygen plates for Immuno-Oncology assays

The Vision
InSimili recreates the real human body microenvironment in vitro, enabling better decisions in pre-clinical studies and reducing in vivo testing. Helping develop new therapies more efficiently and safely.
Our Solution
Cells experience different oxygen availability in the body. Our patented coating regulates the concentration of oxygen at the microscale. Mimicking unique conditions found in patients in vitro.
Our technology is standard compliant, cost-effective, and scalable. Unlocking the potential of testing in hypoxic and physiological oxygen conditions from high throughput screening to complex 3D models.
Democratizing access to Physiological Oxygen
Test Oxygen Anywhere
No need for Hypoxic hoods or special incubators. Our technology regulates oxygen directly in the wells, so you can maximize your lab space and integrate the plates anywhere in your workflow.
Reach Hypoxia in minutes
The specialized well coating modulates oxygen quickly and in proximity of the cells, reaching the target concentration in minutes and maintaining it unperturbed for days.
Convenient and Scalable
The multiwell format allows you to test multiple oxygen levels at once. It’s a precise, ready-to-use solution that integrates effortlessly with your existing protocols and scales with them.
Our Team
InSimili started in 2021 as a spin-off of the University of Bologna. Its proprietary technology was invented by Professor Stefania Rapino's group, with world-class expertise in electrochemical sensing, soft-matter science, and cellular chemistry.
Enrico Grassilli, CEO
Previously, Lead microfluidics Engineer at a biotech startup in Silicon Valley.
Marco Malferrari, PhD. CSO
Jr. Assistant professor at the University of Bologna. Expert in biology and cell cultures.
Prof. Stefania Rapino CTO
Associate Professor of Chemistryat the University of Bologna. Main inventor of the InSimili technology.
Our Partners and Supporters








